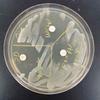

| ||||
Science Image Library
The SPO Science Image Library is a continuously growing collection of copyright- free science photographs. If you use one of our free, lo-res images, we just ask that you give us credit and provide a link to the SPO website (scienceprofonline.com). To enlarge the photo, click on it. To save a photo to your computer, right click on it and select "Save".
Science Image Library
from Science Prof Online
 | ||||||
1.Bat house mounted on oak tree; 2. Eastern Tiger Swallowtail Butterfly on Purple Cone Flower; 3. Cicada exoskeletons; 4. Female English Bulldog; 5. Koi in pond
1.Catecholase experiment: apple with lemon juice on left, apple without on right;
2. Carbohydrates: jelly beans;
3. Bromelain experiment: Jell-O with canned pineapple, left (solid) & fresh pineapple, right (liquid).
1.Blue eyes, a recessive trait; 2. Curved little finger, a dominant trait; 3. Free earlobe, a dominant trait; 4. Ability to roll tongue, a dominant trait;
5. Folding hands with left thumb on top, a dominant trait.
1.Blood agar showing beta-hemolysis from Streptococcus pyogenes growth;
2. Safranin stain, last step of Gram-staining procedure; 3: M. smeg written in Mycobacteria smegmatis & growing on TSY agar; 4. Zones of inhibition from antibiotic discs on plate swabbed with liquid bacterial sample;
5. Compound light microscope.
1.Coleus leaf, example of a dicot; 2. Hawaiian torch ginger flower; 3. Star moss Tortula ruralis; 4. Red oak (Quercus rubra) bark; 5. Super cool looking tree. Anyone know what species it is?
1.Autoclave; 2. Microincinerator; 3. Disposable pipette; 4. Compound light microscope; 5. Inoculation wand on Petri dish of TSY agar.
1.Compost bin; 2. Genetics PowerPoint slide printout; 3. Scantron exam form;
4. Yogurt; 5. Girl sneezing
Miscellaneous Science Photos (Click on image to enlarge.)
1. Cat dissection, ventral surface; 2. Cat dissection,ventral superficial muscles; 3.Cat dissection, dorsal surface; 4. Trans plane anatomical position, 5. Anatomical position
Anatomy/Physiology Photos (Click on image to enlarge. See more)
Animal Photos (Click on image to enlarge. See more)
Chemistry Photos (Click on image to enlarge.)
Genetics Photos (Click on image to enlarge. See more)
Microbiology Photos (Click on image to enlarge. See more)
Plants & Fungi Photos (Click on image to enlarge. See more)
Scientific Equipment Photos (Click on image to enlarge. See more)
Earth Science Photos (Click on image to enlarge.)
1.Grand Canyon of the Yellowstone; 2. Braided River (Denali National Park) 3. Palisade Falls with basalt columns, Montana; 4.Castle Geyser, Yellowstone NP; 5. 45th Parallel, Montana
General Biology Microscopic Specimen Photos
(Click to enlarge. See more)
1.Letter "e" @ 100xTM; 2. Stained cheek epithelial cells @ 400xTM; 3. Elodea plant cells @ 100xTM; 4. Onion epidermis plant cells @ 400xTM; 5.
Elodea plant cells @ 400xTM.
Page last updated: 10/2015
Eukaryotic Cells & Microbe Photos (Click on image to enlarge.
1.Trichinella spirallis in muscle tissue @100xTM; 2. Pumpkin stem 40xTM;
3. Formaifera @100xTM; 4. Obelia sp. @40xTM;
5. Deer tick Ixodes dommini nymph @40xTM.
SPO VIRTUAL CLASSROOMS
Science Image Main Topic Areas
Currently our largest photo collections are in the topic areas of Microbiology, Scientific Equipment and Plants & Fungi.
For those in need of high-resolution images, we will soon be offering hi-res files of many photos in the Science Image Library. If you need a high resolution photo now, please
SCIENCE VIDEOS
 | ||||
Classroom-tested Biology Homework Assignments
FREE from
ScienceProfOnline.com
Classroom-tested science PPT lectures
FREE from
ScienceProfOnline.com
 | ||||
SPO HOME SCIENCE PROJECT
BULLFROG METAMORPHOSIS
We are raising tadpoles and documenting their metamorphosis into adult frogs! Click here to take a look!
Betty's Chicks
10 Days Old
This spring we're tracking two robin nests on our property. Take a peek at our photos of the chicks as they grow!
You have FREE access to a large collection of materials used in a college-level introductory biology course. The Virtual Biology Classroom provides a wide range of free educational resources including PowerPoint Lectures, Study Guides, Review Questions & Practice Test Questions.
 | ||||||
SPO is a FREE science education website. Donations are key in helping us provide this resource with fewer ads.
Please help!
(This donation link uses PayPal on a secure connection.)
 | ||||
NEW SPO HOME SCIENCE PROJECT!!
Betta Fish Care
& Breeding
Follow the saga of Chelsea & Kevin, two star-crossed rather grouchy Siamese fighting fish.
Their love has blossomed and Kevin is now tending a bubble nest full of eggs!
Click here to learn more!
Go to free >
Page last updated: 10/2015